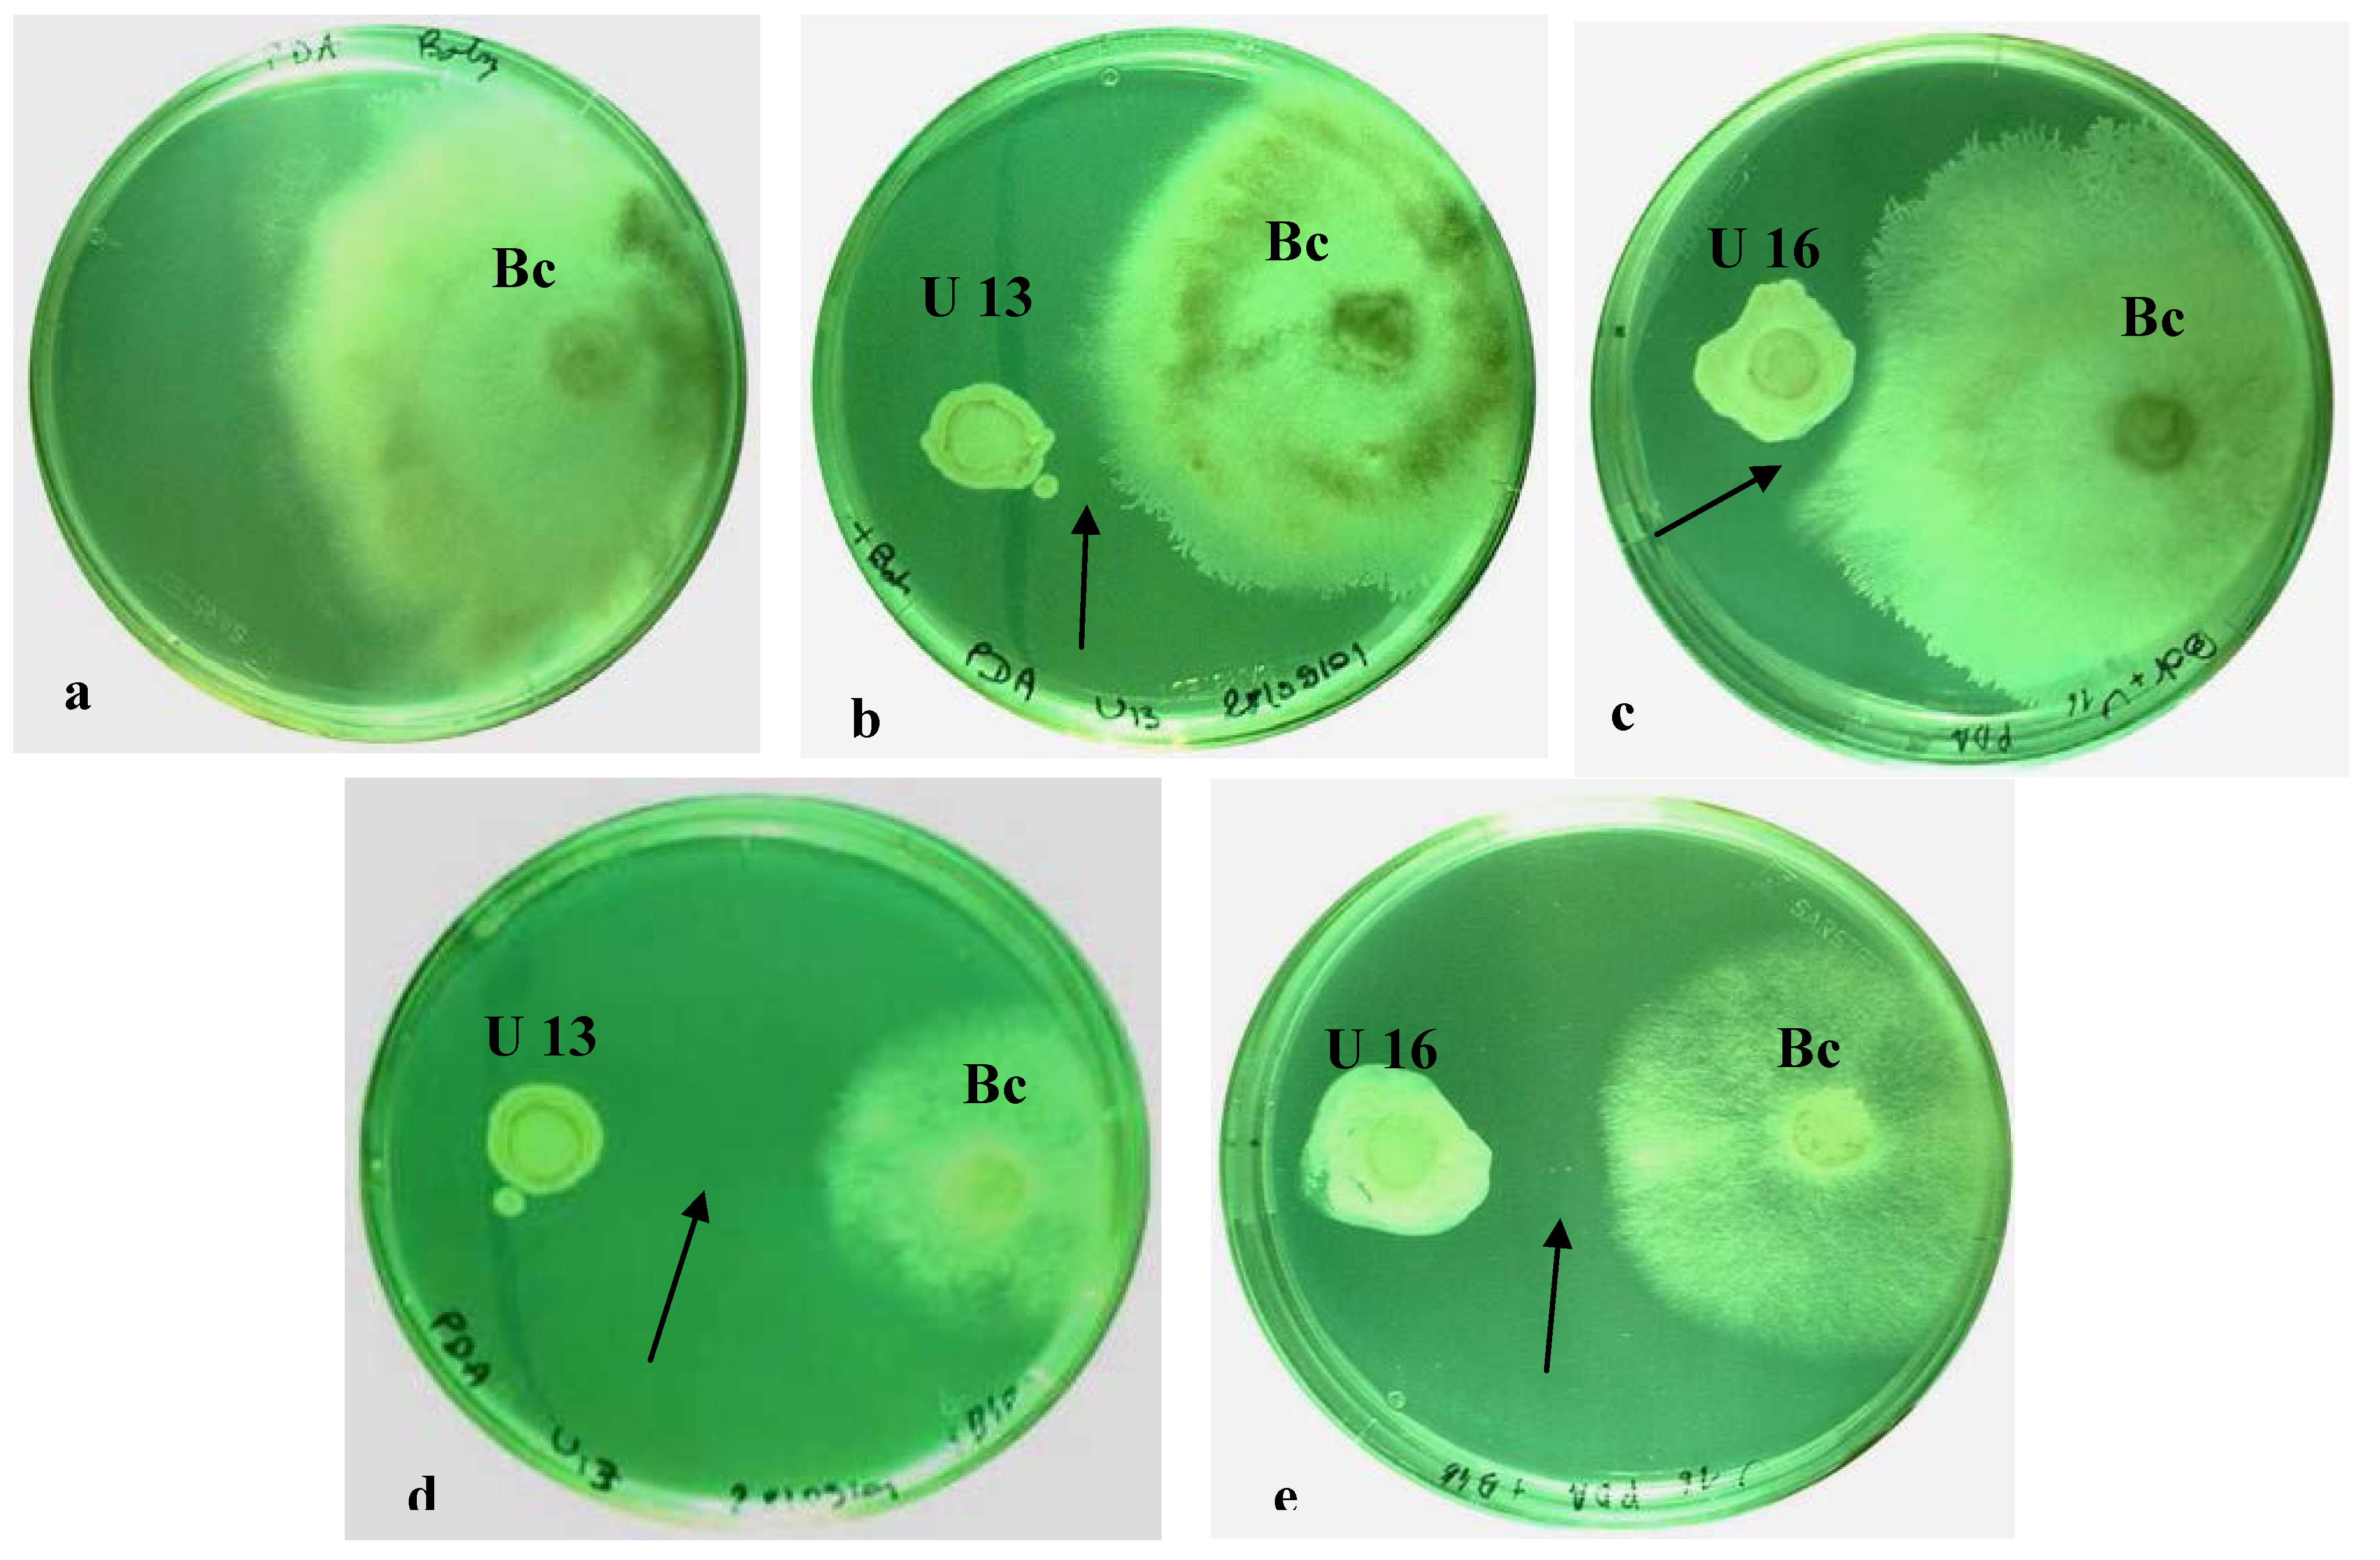
Agronomy 03 00632 g001

Interaction of Ulocladium atrum, a Potential Biological Control Agent, with Botrytis cinerea and Grapevine Plantlets
Abstract
:1. Introduction
2. Results
2.1. In Vitro Dual Cultures

2.2. Plant Resistance
2.3. Electrolytes Leakage Analysis

| Electrolyte leakage (%) | |
|---|---|
| Control | 11.0a |
| B. cinerea | 67.0b |
| U. atrum U13 | 13.0c |
| U. atrum U16 | 14.5c |
| U. atrum U13 + B. cinerea | 16.7c |
| U. atrum U16 + B. cinerea | 17.0c |
2.4. Light Microscope Analysis
2.5. Chitinase Activity


2.6. In Vitro Colonization with U. atrum

3. Experimental Section
3.1. Ulocladium atrum Isolates
3.2. Botrytis Cinerea Culture
3.3. In Vitro Dual Cultures
3.4. Plant Inoculation
3.5. Electrolytes Leakage Assessment
3.6. Tissue Processing for Light Microscope Study
3.7. Protein Extraction and Chitinase Activity Assay
3.8. In Vitro Colonization with Isolates of U. atrum
3.9. Statistical Analyses
4. Conclusions
Conflicts of Interest
References
- Kretschmer, M.; Leroch, M.; Mosbach, A.; Walker, A.S.; Fillinger, S.; Mernke, D.; Schoonbeek, H.J.; Pradier, J.M.; Leroux, P.; de Waard, M.A.; et al. Fungicide-driven evolution and molecular basis of multidrug resistance in field populations of the grey mould fungus Botrytis cinerea. PLoS Pathog. 2009, 5, e1000696. [Google Scholar] [CrossRef]
- Saladin, G.; Magné, C.; Clément, C. Stress responses of Vitis vinifera L. to the fungicides fludioxonil and pyrimethanil. Pestic. Biochem. Phys. 2003, 77, 125–137. [Google Scholar] [CrossRef]
- Compant, S.; Duffy, B.; Nowak, J.; Clément, C.; Ait Barka, E. Use of plant growth-promoting bacteria for biocontrol of plant diseases: Principles, mechanisms of action, and future prospects. Appl. Environ. Microbiol. 2005, 71, 4951–4959. [Google Scholar] [CrossRef]
- Yohalem, D.; Nielsen, K.; Green, H.; Funck Jensen, D. Biocontrol agents efficiently inhibit sporulation of Botrytis aclada on necrotic leaf tips but spread to adjacent living tissue is not prevented. FEMS Microbiol. Ecol. 2004, 47, 297–303. [Google Scholar] [CrossRef]
- Köhl, J. Biocontrol of Foliar Diseases in Horticulture: Screening and Application of Ulocladium atrum for Grey Mould Control. In Implementation of Biocontrol in Practice in Temperate Regions—Present and Near Future, Proceedings of the International Workshop at Research Centre Flakkebjerg, Flakkebjerg, Denmark, 1–3 November 2005; Hansen, L., Ed.; Volume 119, pp. 211–218.
- Jacometti, M.A.; Wratten, S.D.; Walter, M. Alternatives to synthetic fungicides for Botrytis cinerea management in vineyards. Aust. J. Grape Wine Res. 2010, 16, 154–172. [Google Scholar] [CrossRef]
- Schoene, P.; Oerke, E.C.; Dehne, H.W. A New Concept for Integrated Control of Gray Mold (Botrytis cinerea) in Grapevine. In Proceedings of British Crop Protection Conference—Pests and Diseases, The Brighton Hilton Metropole Hotel, Brighton, UK, 13–16 November 2000; pp. 1031–1036.
- Roudet, J.; Dubos, B. Evaluation of a Three Year Study of Ulocladium atrum (strain 385) Control Agent of Vine Grey Rot in the Bordeaux Region. In Proceedings of the XIIth International Botrytis symposium, Reims, France, 3–7 July 2000.
- Kohl, J.; Belanger, R.R.; Fokkema, N.J. Interaction of four antagonistic fungi with Botrytis aclada in dead onion leaves: A comparative microscopic and ultrastructural study. Phytopathology 1997, 87, 634–642. [Google Scholar] [CrossRef]
- Köhl, J.; van der Plas, C.H.; Molhoek, W.M.L.; Fokkema, N.J. Effect of interrupted leaf wetness periods on suppression of sporulation of Botrytis allii and B. cinerea by antagonists on dead onion leaves. Eur. J. Plant Pathol. 1995, 101, 627–637. [Google Scholar] [CrossRef]
- Köhl, J.; Molhoek, W.M.L.; Goosen-van der Geijn, H.; Lombaers-van der Plas, C. Potential of Ulocladium atrum for biocontrol of leaf spot through suppression of sporulation of Botrytis spp. BioControl 2003, 48, 349–359. [Google Scholar] [CrossRef]
- Szandala, E.S.; Backhouse, D. Effect of sporulation of Botrytiscinerea by antagonists applied after infection. Australas. Plant Pathol. 2001, 30, 165–170. [Google Scholar] [CrossRef]
- Kessel, G.J. Biological Control of Botrytis spp. by Ulocladium atrum: An Ecological Analysis; Landbouwuniversiteit Wageningen (Wageningen Agricultural University): Wageningen, the Netherlands, 1999. [Google Scholar]
- Sriram, S.; Raguchander, T.; Babu, S.; Nandakumar, R.; Shanmugam, V.; Vidhyasekaran, P.; Balasubramanian, P.; Samiyappan, R. Inactivation of phytotoxin produced by the rice sheath blight pathogen Rhizoctonia solani. Can. J. Microbiol. 2000, 46, 520–524. [Google Scholar]
- Benhamou, N.; Nicole, M. Cell biology of plant immunization against microbial infection: The potential of induced resistance in controlling plant diseases. Plant Physiol. Biochem. 1999, 37, 703–719. [Google Scholar] [CrossRef]
- Hammerschmidt, R. Induced disease resistance, How do induced plants stop pathogens? Physiol. Mol. Plant Pathol. 1999, 55, 77–84. [Google Scholar] [CrossRef]
- Van Loon, L.C.; Bakker, P.A.H.M. Signalling in Rhizobacteria-Plant Interactions. In Ecological Studies. Root Ecology; De Kroon, J., Visser, E.J.W., Eds.; Springer Verlag: Berlin, Gremany, 2004; Volume 168, pp. 287–330. [Google Scholar]
- Shibuya, N.; Minami, E. Oligosaccharide signalling for defence responses in plant. Physiol. Mol. Plant Pathol. 2001, 59, 223–233. [Google Scholar] [CrossRef]
- Derckel, J.P.; Baillieul, F.; Manteau, S.; Audran, J.C.; Haye, B.; Lambert, B.; Legendre, L. Differential induction of grapevine defenses by two strains of Botrytis cinerea. Phytopathology 1999, 89, 197–203. [Google Scholar] [CrossRef]
- Bézier, A.; Lambert, B.; Baillieul, F. Study of defense-related gene expression in grapevine leaves and berries infected with Botrytis cinerea. Eur. J. Plant Pathol. 2002, 108, 111–120. [Google Scholar] [CrossRef]
- Punja, Z.K.; Zhang, Y.Y. Plant chitinases and their roles in resistance to fungal diseases. J. Nematol. 1993, 25, 526–540. [Google Scholar]
- Dalisay, R.; Kuć, J. Persistence of reduced penetration by Colletotrichum lagenarium into cucumber leaves with induced systemic resistance and its relation to enhanced peroxidase and chitinase activities. Physiol. Mol. Plant Pathol. 1995, 47, 329–338. [Google Scholar] [CrossRef]
- Castoria, R.; de Curtis, F.; Lima, G.; Caputo, L.; Pacifico, S.; de Cicco, V. Aureobasidium pullulans (LS-30) an antagonist of postharvest pathogens of fruits: study on its modes of action. Postharvest Biol. Technol. 2001, 22, 7–17. [Google Scholar] [CrossRef]
- Renault, A.S.; Deloire, A.; Letinois, I.; Kraeva, E.; Tesniere, C.; Ageorges, A.; Redon, C.; Bierne, J. β-1,3-glucanase gene expression in grapevine leaves as a response to infection with Botrytis cinerea. Am. J. Enol. Vitic. 2000, 51, 81–87. [Google Scholar]
- Berto, P.; Jijakli, M.H.; Lepoivre, P. Possible role of colonization and cell wall-degrading enzymes in the differential ability of three Ulocladium atrum strains to control Botrytis cinerea on necrotic strawberry leaves. Phytopathology 2001, 91, 1030–1036. [Google Scholar] [CrossRef]
- Hyakumachi, M. Plant-growth-promoting fungi from turfgrass rhizosphere with potential for disease suppression. Soil Microorg. 1994, 44, 53–68. [Google Scholar]
- Kleifeld, O.; Chet, I. Trichoderma harzianum–interaction with plants and effect on growth response. Plant Soil 1992, 144, 267–272. [Google Scholar] [CrossRef]
- Blanchard, L.M.; Björkman, T. The role of auxin in enhanced root growth of Trichoderma-colonized sweet corn. HortScience 1996, 31, 688. [Google Scholar]
- Harman, G.E.; Howell, C.R.; Viterbo, A.; Chet, I.; Lorito, M. Trichoderma species opportunistic avirulent plant simbionts. Nat. Rev. Microbiol. 2004, 2, 43–56. [Google Scholar] [CrossRef]
- Benítez, T.; Rincón, A.M.; Limón, M.C.; Codón, A.C. Biocontrol mechanisms of Trichoderma strains. Int. Microbiol. 2004, 7, 249–260. [Google Scholar]
- Mejia, L.; Rojas, E.; Maynard, Z.; Bael, S.; Arnold, A.; Hebbar, P.; Samuels, G.; Robbins, N.; Herre, E. Endophytic fungi as biocontrol agents of Theobroma cacao pathogens. Biol. Control 2008, 46, 4–14. [Google Scholar] [CrossRef]
- Lee, K.; Pan, J.; May, G. Endophytic Fusarium verticillioides reduces disease severity caused by Ustilago maydis on maize. FEMS Microbiol. Lett. 2009, 299, 31–37. [Google Scholar] [CrossRef]
- Raghavendra, A.; Newcombe, G. The contribution of foliar endophytes to quantitative resistance to Melampsora rust. New Phytol. 2013, 197, 909–918. [Google Scholar] [CrossRef]
- Ait Barka, E.; Nowak, J.; Clement, C. Enhancement of chilling resistance of inoculated grapevine plantlets with a plant growth-promoting rhizobacterium, Burkholderia phytofirmans strain PsJN. Appl. Environ. Microbiol. 2006, 72, 7246–7252. [Google Scholar] [CrossRef]
- Wirth, S.J.; Wolf, G.A. Microplate colorimetric assay for endo-acting cellulase, xylanase, chitinase, β-1,3 glucanase and amylase extracted from forest soil horizons. Soil Biol. Biochem. 1992, 24, 511–519. [Google Scholar] [CrossRef]
- Martin, C.; Vernoy, R.; Carr, M.; Vesselle, G.; Collas, A.; Bougerey, C. The vine and techniques of in vitro cultivation. Bull. Org. Int. Vigne. 1987, 675–676, 447–458. [Google Scholar]
© 2013 by the authors; licensee MDPI, Basel, Switzerland. This article is an open access article distributed under the terms and conditions of the Creative Commons Attribution license (http://creativecommons.org/licenses/by/3.0/).
Share and Cite
Ronseaux, S.; Clément, C.; Barka, E.A. Interaction of Ulocladium atrum, a Potential Biological Control Agent, with Botrytis cinerea and Grapevine Plantlets. Agronomy 2013, 3, 632-647. https://doi.org/10.3390/agronomy3040632
Ronseaux S, Clément C, Barka EA. Interaction of Ulocladium atrum, a Potential Biological Control Agent, with Botrytis cinerea and Grapevine Plantlets. Agronomy. 2013; 3(4):632-647. https://doi.org/10.3390/agronomy3040632
Chicago/Turabian StyleRonseaux, Sébastien, Christophe Clément, and Essaid Ait Barka. 2013. "Interaction of Ulocladium atrum, a Potential Biological Control Agent, with Botrytis cinerea and Grapevine Plantlets" Agronomy 3, no. 4: 632-647. https://doi.org/10.3390/agronomy3040632
APA StyleRonseaux, S., Clément, C., & Barka, E. A. (2013). Interaction of Ulocladium atrum, a Potential Biological Control Agent, with Botrytis cinerea and Grapevine Plantlets. Agronomy, 3(4), 632-647. https://doi.org/10.3390/agronomy3040632

